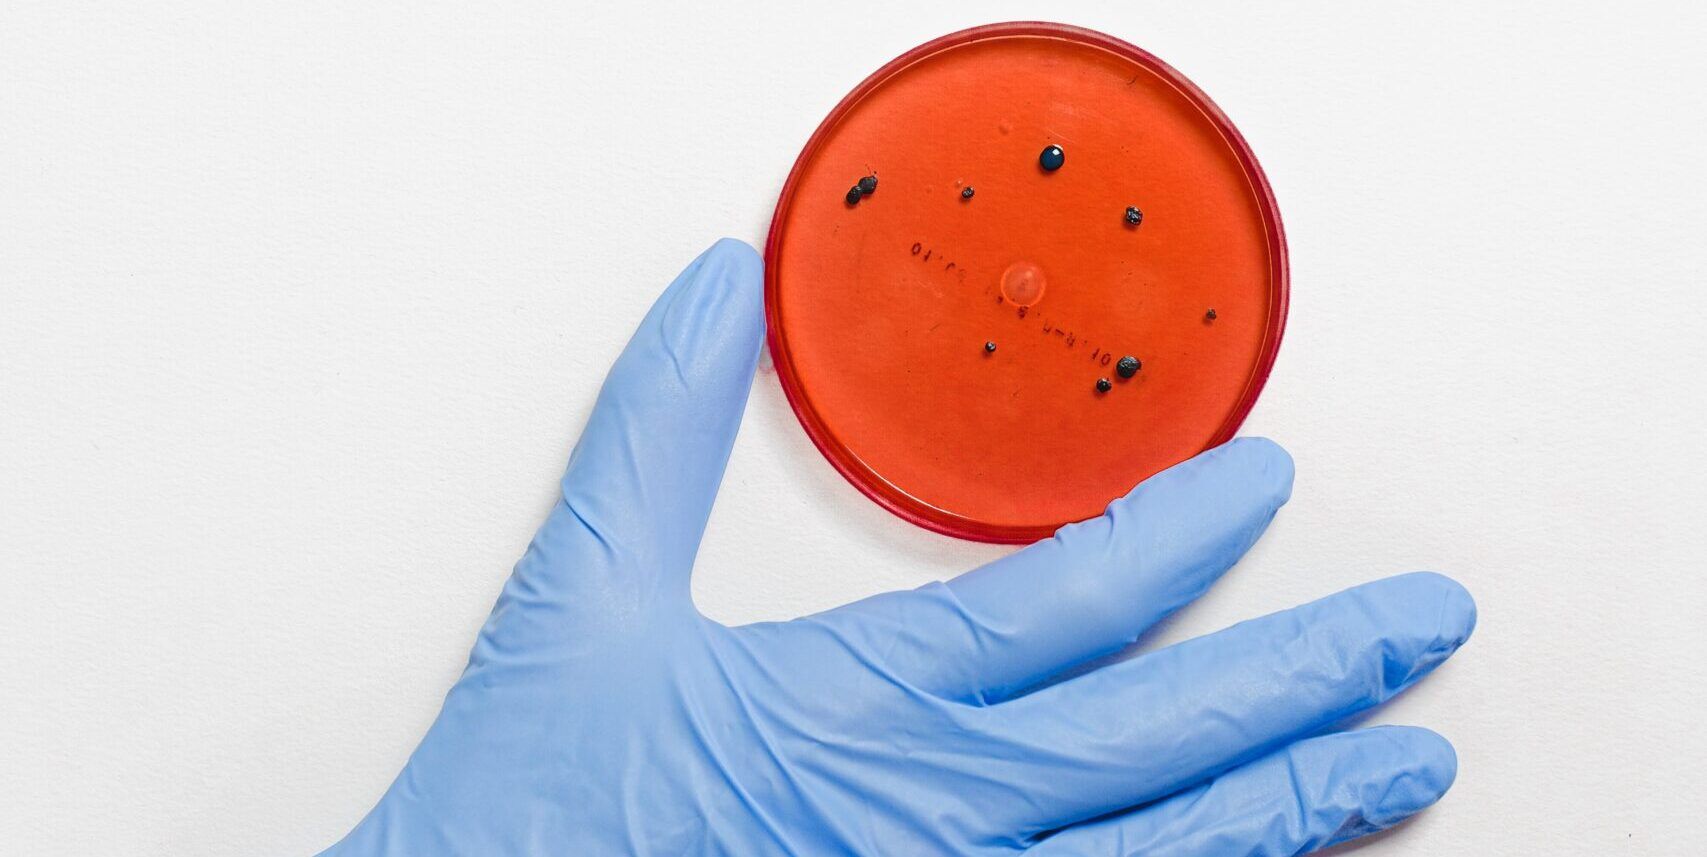
Covid, positivi due studenti: scuole chiuse a Strongoli

Si legge in: 1 minuto
Cambia colore:
coronavirus
Covid, positivi due studenti: scuole chiuse a Strongoli
La decisione del sindaco: stop fino a giovedì per effettuare la sanificazione. Attesa per i tamponi molecolari
Pubblicato il: 16/02/2021 – 19:30
00:00
00:00
Ascolta la versione audio dell'articolo
STRONGOLI Due studenti delle scuole medie di Strogoli sono risultati positivi al Covid 19 insieme ai loro genitori. Diverse persone che sono state in contatto con la famiglia sono ora in attesa di conoscere l’esito dei tamponi molecolari. Il sindaco di Strongoli Sergio Bruno, aspettando di capire l’evolversi della situazione, ha intanto deciso, forma di prevenzione, di chiudere dal 16 al 18 febbraio le scuole cittadine di ogni ordine e grado, pubbliche e private, e di procedere alla sanificazione dei locali. Non ci sono conferme che il contagio dipenda dalla variante inglese del Covid.
Argomenti
Categorie collegate
Ultime dal Corriere della Calabria
Edizioni provinciali